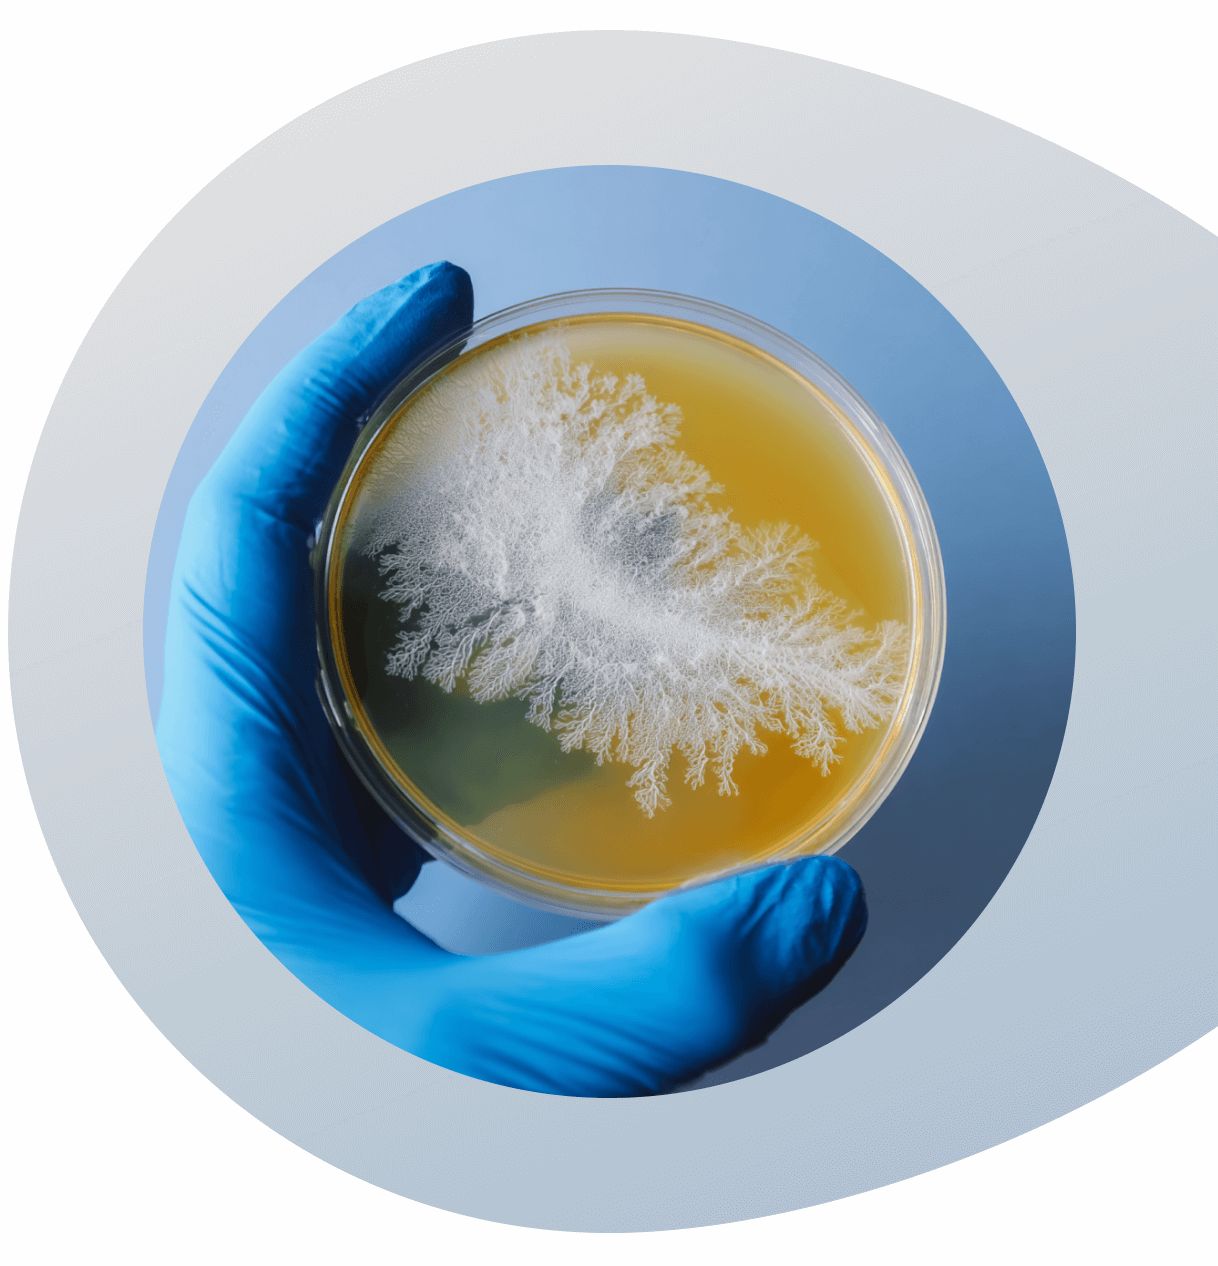
Fungi Mycelium culture plate held by a gloved hand on a white background

Reishi's Most Studied Natural Compounds
Ling Zhi-8
Ganoderic Acids
Ganodermanontriol



Our interest in extracting Reishi began by deep-diving into 50+ publications*.
What is Reishi ?
Reishi (Ganoderma lucidum) is a woody, functional mushroom long revered in traditional Chinese and Japanese practices. Often called the “Mushroom of Immortality,” it grows naturally on decaying hardwoods and is known for its broad range of naturally occurring compounds.
It contains several well-studied bioactive compounds that have been the focus of scientific research, such as β-glucans, ganoderic acids, and phenolics, that are being studied in preclinical research for their potential roles in supporting antioxidant defenses, immune modulation, gut balance, and inflammation regulation.*
Explore our TriExtract formula, combining three organic mushroom extracts : Lion’s Mane, Reishi, and Chaga for all-in-one daily support.
Who is it for?
Our Reishi extract is formulated for:
Adults navigating pressure, change, or long-term wellness goals : Whether it’s parents balancing work and family, adults 50+ experiencing physiological shifts, or athletes managing recovery, Reishi is embraced for its traditional role in promoting internal balance and resilience.
Those seeking natural support for relaxation, gut health, and physical comfort:
Often chosen during periods of stress, inflammation, or digestive discomfort, Reishi fits into routines focused on calm, gut harmony, and long-term well-being.
Did you know?
Cold sore, skin breakouts, or feeling run down can signal your defenses are low. Many turn to Reishi at the first signs, supporting balance before deeper fatigue sets in.
Why ?
Thymic output, responsible for producing new T cells crucial to the immune system, naturally declines by about 3% each year after puberty. By our 60s, this leads to fewer naïve T cells. As a result, the immune system’s adaptability to new infections is reduced, recovery slows, and susceptibility to infections and autoimmune issues increases.*
This age-related shift has contributed to growing interest in wellness routines that support immune resilience.
Among them, Reishi (Ganoderma lucidum) stands out, valued both for its traditional use in promoting immune balance and for the increasing scientific attention on its bioactive compounds and their potential roles in supporting overall well-being.
*Source : The influence of age on T cell generation and TCR diversity - The Journal of Immunology - 2005.
*Scientific Ressources
- MSKCC Integrative Medicine database - Reishi Mushroom
- Wang GH, Wang LH, Wang C, et al. Spore powder of Ganoderma lucidum for the treatment of Alzheimer disease: A pilot study. Medicine (Baltimore). May 2018;97(19):e0636. doi: 10.1097/md.0000000000010636
- Chen HS, Tsai YF, Lin S, et al. Studies on the immuno-modulating and anti-tumor activities of Ganoderma lucidum (Reishi) polysaccharides. Bioorg Med Chem. Nov 1 2004;12(21):5595-5601.
- Gao Y, Zhou S, Wen J, et al. Mechanism of the antiulcerogenic effect of Ganoderma lucidum polysaccharides on indomethacin-induced lesions in the rat. Life Sci. Dec 27 2002;72(6):731-745.
- Hsu MJ, Lee SS, Lin WW. Polysaccharide purified from Ganoderma lucidum inhibits spontaneous and Fas-mediated apoptosis in human neutrophils through activation of the phosphatidylinositol 3 kinase/Akt signaling pathway. J Leukoc Biol. Jul 2002;72(1):207-216.
- Wang SY, Hsu ML, Hsu HC, et al. The anti-tumor effect of Ganoderma lucidum is mediated by cytokines released from activated macrophages and T lymphocytes. Int J Cancer. Mar 17 1997;70(6):699-705.
- Wachtel-Galor S, Szeto YT, Tomlinson B, et al. Ganoderma lucidum (’Lingzhi’); acute and short-term biomarker response to supplementation. Int J Food Sci Nutr. Feb 2004;55(1):75-83.
- Wachtel-Galor S, Tomlinson B, Benzie IF. Ganoderma lucidum (“Lingzhi”), a Chinese medicinal mushroom: biomarker responses in a controlled human supplementation study. Br J Nutr. Feb 2004;91(2):263-269.
- Gao Y, Zhou S, Jiang W, et al. Effects of ganopoly (a Ganoderma lucidum polysaccharide extract) on the immune functions in advanced-stage cancer patients. Immunol Invest. Aug 2003;32(3):201-215.
- Shieh YH, Liu CF, Huang YK, et al. Evaluation of the hepatic and renal-protective effects of Ganoderma lucidum in mice. Am J Chin Med. 2001;29(3-4):501-7.
- Noguchi M, Kakuma T, Tomiyasu K, et al. Randomized clinical trial of an ethanol extract of Ganoderma lucidum in men with lower urinary tract symptoms. Asian J Androl. Sep 2008;10(5):777-785.
- Tao J, Feng KY. Experimental and clinical studies on inhibitory effect of Ganoderma lucidum on platelet aggregation. J Tongji Med Univ. 1990;10(4):240-243.
- Wang CZ, Basila D, Aung HH, et al. Effects of Ganoderma lucidum extract on chemotherapy-induced nausea and vomiting in a rat model. Am J Chin Med. 2005;33(5):807-815.
- Gill SK, Rieder MJ. Toxicity of a traditional Chinese medicine, Ganoderma lucidum, in children with cancer. Can J Clin Pharmacol. Summer 2008;15(2):e275-285.
- Wang X, Zhao X, Li D, et al. Effects of Ganoderma lucidum polysaccharide on CYP2E1, CYP1A2 and CYP3A activities in BCG-immune hepatic injury in rats. Biol Pharm Bull. Sep 2007;30(9):1702-1706.
- Chen NH, Liu JW, Zhong JJ. Ganoderic Acid me inhibits tumor invasion through down-regulating matrix metalloproteinases 2/9 gene expression. J Pharmacol Sci. Oct 2008;108(2):212-216.
- Li YB, Wang R, Wu HL, et al. Serum amyloid A mediates the inhibitory effect of Ganoderma lucidum polysaccharides on tumor cell adhesion to endothelial cells. Oncol Rep. Sep 2008;20(3):549-556.
- Chan WK, Cheung CC, Law HK, et al. Ganoderma lucidum polysaccharides can induce human monocytic leukemia cells into dendritic cells with immuno-stimulatory function. J Hematol Oncol. 2008;1(1):9.
- Noguchi M, Kakuma T, Tomiyasu K, et al. Effect of an extract of Ganoderma lucidum in men with lower urinary tract symptoms: a double-blind, placebo-controlled randomized and dose-ranging study. Asian J Androl. 2008 Jul;10(4):651-8.
- Weng CJ, Yen GC. The in vitro and in vivo experimental evidences disclose the chemopreventive effects of Ganoderma lucidum on cancer invasion and metastasis. Clin Exp Metastasis. 2010 May;27(5):361-9.
- Kim KC, Jun HJ, Kim JS, Kim IG. Enhancement of radiation response with combined Ganoderma lucidum and Duchesnea chrysantha extracts in human leukemia HL-60 cells. Int J Mol Med. 2008 Apr;21(4):489-98.
- Gordan JD, Chay WY, Kelley RK, et al. “And what other medications are you taking?”. J Clin Oncol. 2011 Apr 10;29(11):e288-91.
- Yuen MF, Ip P, Ng WK, Lai CL. Hepatotoxicity due to a formulation of Ganoderma lucidum (lingzhi). J Hepatol. 2004 Oct;41(4):686-7.
- Wanmuang H, Leopairut J, Kositchaiwat C, Wananukul W, Bunyaratvej S. Fatal fulminant hepatitis associated with Ganoderma lucidum (Lingzhi) mushroom powder. J Med Assoc Thai. 2007 Jan;90(1):179-81.
- Wanachiwanawin D, Piankijagum A, Chaiprasert A, et al. Ganoderma lucidum: a cause of pseudoparasitosis. Southeast Asian J Trop Med Public Health. 2006 Nov;37(6):1099-102.
- Zhao S, Ye G, Fu G, Cheng JX, Yang BB, Peng C. Ganoderma lucidum exerts anti-tumor effects on ovarian cancer cells and enhances their sensitivity to cisplatin. Int J Oncol. 2011 May;38(5):1319-27.
- Pillai TG, John M, Sara Thomas G. Prevention of cisplatin induced nephrotoxicity by terpenes isolated from Ganoderma lucidum occurring in Southern Parts of India. Exp Toxicol Pathol. 2011 Jan;63(1-2):157-60.
- Chu TT, Benzie IF, Lam CW, et al. Study of potential cardioprotective effects of Ganoderma lucidum (Lingzhi): results of a controlled human intervention trial. Br J Nutr. 2012 Apr;107(7):1017-27.
- Jin X, Ruiz Beguerie J, Sze DM, Chan GC . Ganoderma lucidum (Reishi mushroom) for cancer treatment. Cochrane Database Syst Rev. 2012 Jun 13;6:CD007731.
- Chang CJ, Chen YY, Lu CC, et al. Ganoderma lucidum stimulates NK cell cytotoxicity by inducing NKG2D/NCR activation and secretion of perforin and granulysin. Innate Immun. 2014 Apr;20(3):301-11.
- Sun LX, Lin ZB, Duan XS, et al. Enhanced MHC class I and costimulatory molecules on B16F10 cells by Ganoderma lucidum polysaccharides. J Drug Target.2012 Aug;20(7):582-92.
- Boh B, Berovic M, Zhang J, Zhi-Bin L. Ganoderma lucidum and its pharmaceutically active compounds. Biotechnol Annu Rev. 2007;13:265-301.
- Paterson RR. Ganoderma - a therapeutic fungal biofactory. Phytochemistry. 2006 Sep;67(18):1985-2001.
- Liang Y, He M, Fan X, et al. An abnormal elevation of serum CA72-4 by Ganoderma lucidum spore powder. Ann Clin Lab Sci. 2013 Summer;43(3):337-40.
- Joseph S, Sabulal B, George V, Antony KR, Janardhanan KK. Antitumor and anti-inflammatory activities of polysaccharides isolated from Ganoderma lucidum. Acta Pharm. 2011 Sep 1;61(3):335-42.
- Jin H, Jin F, Jin JX, et al. Protective effects of Ganoderma lucidum spore on cadmium hepatotoxicity in mice. Food Chem Toxicol. 2013 Feb;52:171-5.
- Klupp NL, Chang D, Hawke F, et al. Ganoderma lucidum mushroom for the treatment of cardiovascular risk factors. Cochrane Database Syst Rev. 2015;2:CD007259.
- Ko KK, Murthee KG, Koh TH, et al. Reishi (lingzhi) ingestion mistaken for persistent Clonorchis infection. Pathology. Oct 2014;46(6):576-578.
- Sun LX, Li WD, Lin ZB, et al. Protection against lung cancer patient plasma-induced lymphocyte suppression by Ganoderma lucidum polysaccharides. Cell Physiol Biochem. 2014;33(2):289-299.
- Oka S, Tanaka S, Yoshida S, et al. A water-soluble extract from culture medium of Ganoderma lucidum mycelia suppresses the development of colorectal adenomas. Hiroshima J Med Sci. Mar 2010;59(1):1-6.
- Yan B, Meng X, Shi J, et al. Ganoderma lucidum spore induced CA72-4 elevation in gastrointestinal cancer: a five-case report. Integr Cancer Ther. Mar 2014;13(2):161-166.
- Klupp NL, Kiat H, Bensoussan A, et al. A double-blind, randomised, placebo-controlled trial of Ganoderma lucidum for the treatment of cardiovascular risk factors of metabolic syndrome. Sci Rep. Aug 11 2016;6:29540.
- Jin X, Ruiz Beguerie J, Sze DM, et al. Ganoderma lucidum (Reishi mushroom) for cancer treatment. Cochrane Database Syst Rev. Apr 05 2016;4:Cd007731.
- Wang C, Shi S, Chen Q, et al. Antitumor and Immunomodulatory Activities of Ganoderma lucidum Polysaccharides in Glioma-Bearing Rats. Integr Cancer Ther. Sep 2018;17(3):674-683.
- Wu K, Na K, Chen D, et al. Effects of non-steroidal anti-inflammatory drug-activated gene-1 on Ganoderma lucidum polysaccharides-induced apoptosis of human prostate cancer PC-3 cells. Int J Oncol. Dec 2018;53(6):2356-2368.
- Guggenheim AG, Wright KM, Zwickey HL. Immune Modulation From Five Major Mushrooms: Application to Integrative Oncology. Integr Med (Encinitas). Feb 2014;13(1):32-44.
- Liu J, Mao JJ, Li SQ, Lin H. Preliminary Efficacy and Safety of Reishi & Privet Formula on Quality of Life Among Non-Small Cell Lung Cancer Patients Undergoing Chemotherapy: A Randomized Placebo-Controlled Trial. Integr Cancer Ther. 2020 Jan-Dec;19:1534735420944491.
- Pazzi F, Adsuar JC, Domínguez-Muñoz FJ, et al. Effects of Ganoderma lucidum and Ceratonia siliqua on blood glucose, lipid profile, and body composition in women with fibromyalgia. Nutr Hosp. 2021 Feb 23;38(1):139-145.
- Liu H, Wang ZY, Zhou YC, Song W, Ali U, Sze DM. Immunomodulation of Chinese Herbal Medicines on NK cell populations for cancer therapy: A systematic review. J Ethnopharmacol. 2021 Mar 25;268:113561.
- Deng Y, Ma J, Tang D, Zhang Q. Dynamic biomarkers indicate the immunological benefits provided by Ganoderma spore powder in post-operative breast and lung cancer patients. Clin Transl Oncol. 2021 Jul;23(7):1481-1490.
- Kogure T, Koiwai A, Fukushi D, et al. Hypereosinophilia with Hepatic Nodule Formation Caused by Ganoderma lucidum. Intern Med. 2021;60(24):3897-3903.
- Rodseeda C, Yamanont P, Pinthong D, Korprasertthaworn P. Inhibitory effects of Thai herbal extracts on the cytochrome P450 3A-mediated the metabolism of gefitinib, lapatinib and sorafenib. Toxicol Rep. 2022 Oct 4;9:1846-1852.
- Yasuyo Hijikata, Seika Yamada, Akihiro Yasuhara, Herbal mixtures containing the mushroom Ganoderma lucidum improve recovery time in patients with herpes genitalis and labialis. Clinical TrialJ Altern Complement Med.2007 Nov; 13(9):985-7.
Most Reishi Supplements Stop at Standard. We Don’t.
Every detail, from sourcing to formulationn is considered to ensure that when you choose Polyextract, you’re choosing an extract that goes far beyond industry standards.
No shortcuts. No compromises. Just premium quality, start to finish.
-

Vegan
-

Gluten-Free
-

Certified Organic
-

No Animal Testing
-

No-Binders
-

Allergen-Free
-

100% EU Ingredients
-

GMO-Free
Making each dose work harder for you.
Questions ? We're here to help you.
How do I take Reishi Extract ?
Take x1 full dropper pipette (1 mL) per day.
Mix it into a glass of water or any other cold liquid.You can also take it directly under the tongue.
________________
For best results:
- Take consistently. Reishi works best when used daily over time.
- Avoid mixing with hot liquids, as heat may affect the stability of some sensitive compounds.
- Take at the same time each day, ideally within one hour of your usual wake-up and wind-down times to stay aligned with your circadian rhythm.
- During high-demand periods (mental or physical), you may temporarily increase to 30–40 drops per day (1.5 to 2 full pipettes), split between morning and evening.
- Start with 5 drops in the morning and 5 in the evening. Then, Increase daily by +2 drops total (add 1 drop to each dose) until you reach 20 drops per day by day 6 (10 in the morning, 10 in the evening).
- Always Shake well before use.
________________
x1 dropper pipette = 1 mL = 0.0338 oz. ≈ x20 dropps
Do not exceed 50 drops per day.
Do not use if under 18 years old, or if you are a pregnant/breastfeeding women.
What’s Inside the Reishi Extract ?
Organic Reishi - Ganoderma lucidum - (Liquid Extract)
- 100% Organically Grown - Certified Organic by Ecocert (EU Agriculture)
- Fruiting Body (100%)
- Mushroom Origin: Belgium (BE)
Other Ingredients: Purified Water, Food Grade Organic Ethanol (20-24%)*
And nothing else !
*Note: Ethanol is used as a solvent to extract and stabilize bioactive compounds and enhance product bioavailability.
Why should I choose Polyextract Supplement ?
Reishi is traditionally used by individuals looking to support balance during times of physical tension, stress, or physiological change. It's embraced by those who value natural support for immune function, relaxation, and recovery, without resorting to synthetic alternatives.
At Polyextract, our triple-extracted liquid Reishi delivers a broad spectrum of naturally occurring compounds in a bioavailable form your body can absorb more efficiently.
Compared to raw mushroom or standard powders, our extract offers superior bioavailability and fits effortlessly into your daily routine.
When will I feel something?
Some users report subtle effects such as improved mood, focus, or a steadier sense of energy within the first week. Others begin to notice sleep quality or general well-being shift after 1–2 weeks of consistent use.
The most commonly reported benefits, supporting immune balance, energy stability, and overall resilience, typically emerge after 2 to 4 weeks. For full effect, daily use over 1 to 3 months is often recommended.
As with any supplement, individual response varies. Reishi is not about instant change, it’s about building long-term balance through consistent use and full benefits developing over several weeks to months of regular use.
What does Reishi Mushroom extract do?
Polyextract Reishi extract is made from organic fruiting bodies and contains naturally occurring compounds such as β-glucans, ganoderic acids, and phenolics. These compounds are being studied in preclinical research for their potential to support immune balance, help regulate inflammation, and contribute to general well-being.
You can explore the studies related to these compounds in our Scientific Reference Library.
Can I take Reishi extract with other supplements or medications?
Yes, many people include Reishi in their supplement routine, and there are no known contraindications for most users.
However, our herbal and fungal extracts are highly concentrated. If combining with other supplements, we recommend spacing out doses and monitoring how your body responds.
As a general rule, if you are on prescription medication or managing a serious health condition, we recommend consulting your healthcare provider before use to ensure safe and appropriate integration into your wellness routine. Reishi may influence immune and blood-related functions. Extra caution is advised if you're taking medications such as immunosuppressants, anticoagulants / blood thinners drugs.
Who It’s For ?
Our Reishi extract is formulated for:
Adults from 30 to 80+, navigating life's changing rhythms
From professionals managing mental load to parents juggling family demands and older adults experiencing physiological changes, Reishi is traditionally used to support internal balance and adaptability.
Those integrating natural support into daily wellness
Whether dealing with occasional stress, digestive discomfort, or physical strain, many turn to Reishi to help maintain calm, support gut harmony, and promote steady well-being over time.
Noticing the tingle of a cold sore or feeling unusually run down?
These can be early signs that signal your defenses are low. Reishi is often added at the first signs of imbalance to help support the body’s natural rhythms and maintain internal balance, before deeper fatigue sets in.